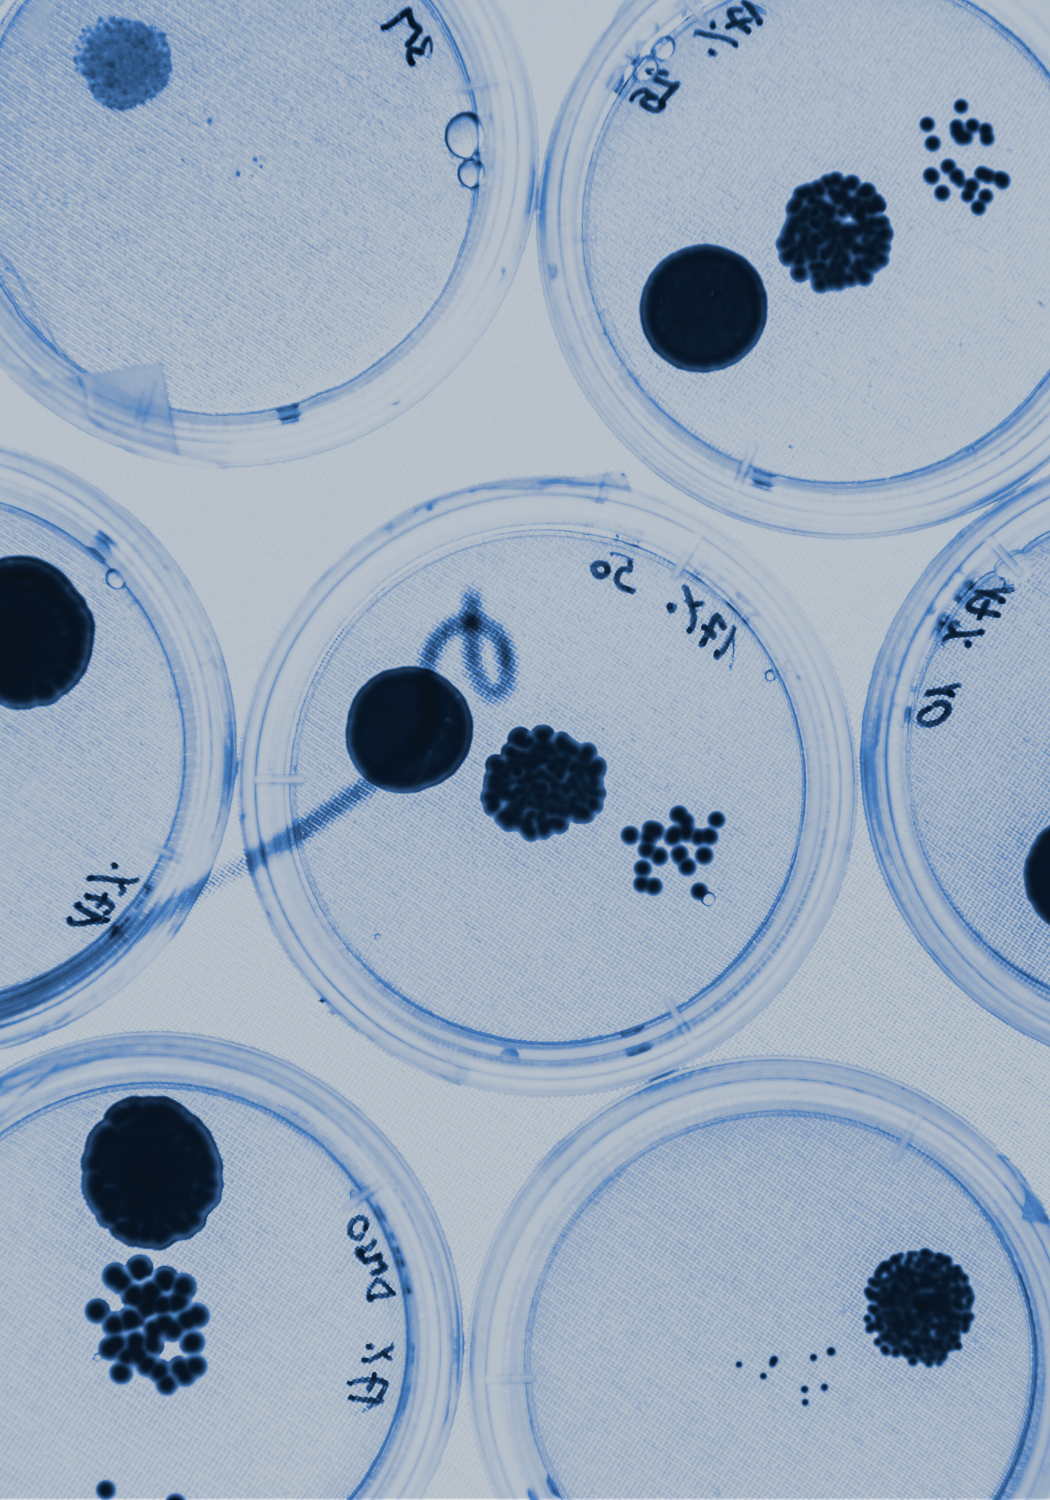

Free Resources
Your Go-To Library for Food Safety Tools, Tips, and Training
Welcome to our Free Resources library - your one-stop destination for practical tools and expert insights to help you tackle food safety challenges with confidence.
Whether you’re looking for quick-reference guides, short videos, mini-courses, or webinar recordings, you’ll find a wealth of resources designed to make your work easier and more impactful. Best of all, it’s completely free!
Explore and start building your food safety skills today.

Good Manufacturing Practices
Food safety basics
Good Manufacturing Practices (GMPs) are the everyday actions that keep food safe. This quick video breaks down the most common GMPs and why they matter in food manufacturing. Perfect for new employees or a quick refresher!

How to Write a Valid Non-Conformance
Free Training
This training focuses on perfecting the skill of writing non-conformances (NCs), because how we write NCs has a huge impact on whether people trust and respect the quality of our work. Learn how to easily write solid (and valid) non-conformances, and how to recognize invalid non-conformances.
Micro 101 & EMP 101
Mini-Course
This mini-course is designed to give you the foundational knowledge you need, without the fluff. Whether you're in packaging, distribution, or any part of the food manufacturing industry where microbes aren't top of mind, this course will help you understand the essentials and confidently explain why you do—or don't—need to worry about microbiological controls.

CAPA Hub
Tools & Resources
Get instant access to webinars, quick videos, essential tools and guides to improve your CAPA & RCA processes. Simplify complex concepts, empower your team, and foster a collaborative and proactive approach to food safety.

Building to Scale
Interactive Guide
Explore the key stages of building a food business, from getting started to scaling up. This interactive guide offers practical tips on regulations, certifications, and essential steps at each stage to help you grow with confidence. Whether you're just launching or expanding to new markets, find out what it takes to reach the next level.

YouTube Channel
Deep Dives & Quick Wins
Discover food safety in a whole new way with our YouTube channel! Packed with videos ranging from short and engaging to full-length webinars, we cover topics like HACCP basics, corrective actions, and GMPs. Make it your new go-to resource for quick learning and practical tips!

Blog
Food Safety Insights
Stay up to date with the latest in food safety through our blog. We break down complex topics into clear, actionable advice, covering trends, best practices, and real-world solutions to help you improve your food safety programs.